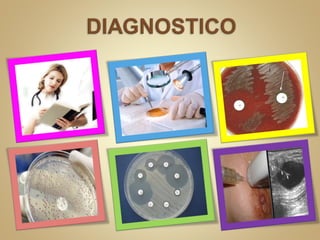
Celulitis Infecciosa

Incrustar presentación
Descargado 711 veces














Las bacterias más comunes que causan celulitis después de una mordedura de perro incluyen estreptococos, pasteurella multocida, haemophilus, capnocytophaga canimorsus, estafilococos aureus y eikenella corrodens. La celulitis puede manifestarse localmente en la piel o extenderse a la órbita ocular.